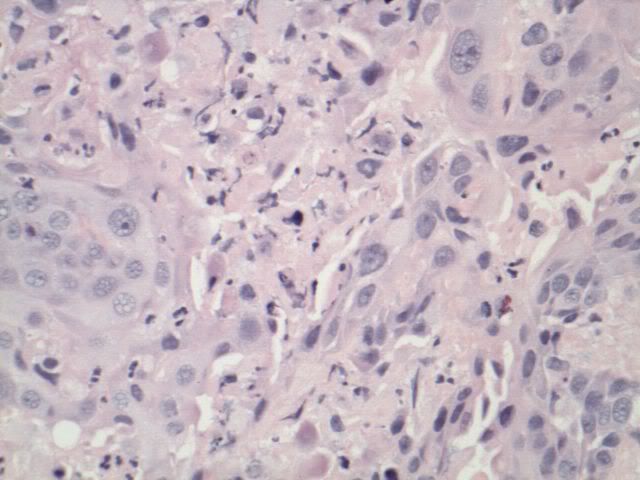
Photobucket

The cervix is the lower, narrow end of the uterus (the hollow, pear-shaped organ where fetus grows).The cervix leads from the uterus to the vagina (birth canal). The function of cervix is to allow flow of menstrual blood from the uterus into the vagina, and direct the sperms through cervical mucus into the uterus during intercourse. The narrow and tight cervical canal stabilizes and protects the foetus during pregnancy. During labor, body hormones and pressure from fetal head widens the canal to about 4 inches, to allow birth of a baby.


http://www.tqnyc.org/2006/NYC063547/images/femalereproductivesystem.jpg
http://www.proscreen.co.uk/image12.jpg
What is Cancer?
Cancer involves the uncontrolled division of cells. Normal cells have proto-oncogenes whose functions are to promote normal growth and division of cells. Cancerous cells have oncogenes, which are mutated forms of proto-oncogenes which cause cells to divide excessively.
Normal cells have tumour suppressor genes which prevent or suppress cell growth and division. Mutations occur in these genes causing cells to grow and divide in an uncontrolled manner, leading to cancer.
Tumor is a mass of cancerous cells. Some cancerous cells may spread to other parts of body via blood vessels or lymphatic system and causes secondary cancer at other location. (Malignant)
 http://www.topnews.in/files/CancerCells22.jpg
http://www.topnews.in/files/CancerCells22.jpgCervical Cancer (Definition)
Cervical Cancer is the most common cancer of female reproduction system. It usually develops slowly over time and is often symptomless. Before cancer appears in the cervix, the cervix undergoes dysplasia, in which cells that are abnormal begin to appear in the cervical tissue. Later malignant cells start to grow and spread more deeply into the cervix and to surrounding areas.

http://www.ansci.wisc.edu/jjp1/ansci_repro/misc/project_websites_08/tues/HPV/HPV1.jpg
Cervical Cancer (Causes)
There are over 100 different types of human papilloma virus (HPV). For most people, HPV is harmless and goes away without treatment. Some HPV types are called the ‘wart virus’ or ‘genital wart virus’ as they cause genital warts. HPV is the major cause of main types of cervical cancer-squamous cell cancer and adenocarcinoma. But some types of HPV are considered ‘high risk’ for cervical cancer –they include types 16, and 18.
Healthy cervical cell
http://www.cap.org/apps/docs/reference/myBiopsy/images/NORMAL_CERVIX_400X.jpg
Cancerous cervical cell
http://www.cap.org/apps/docs/reference/myBiopsy/images/Invasive_cscc_400x.jpg

http://missinglink.ucsf.edu/lm/IDS_107_Cervix_Ovary_Uterus/homepage.htm
Squamous Cells are the flat skin-like cells covering the outer surface of cervix. Squamous cell is the most common type of cervical cancer.
 DNA Of Cervical Cancer
DNA Of Cervical Cancer
http://www.gfmer.ch/selected_images_v2/detail_list.php?cat1=4&cat2=24&cat3=559&cat4=5&stype=n

http://z.about.com/f/p/440/graphics/images/en/17034.jpg

http://www.hpvinformation.com/About-HPV/~/media/Images/QIAGENCMS/Corporate/Web/TheHPVTest/FAQs/CervicalCancerEducational.ashx
Adenomatous cells are gland cells that produce mucus. The cervix has these gland cells scattered along the inside of the passageway that runs from the cervix to the womb (endocervical canal). Adenocarcinoma is cancer of these gland cells. It is less common than squamous cell cancer, but has become more common in recent years. Between 1 in 10 and 1 in 20 cases of cervical cancer are adenocarcinoma.
Sexual History
Women has a higher than average risk of developing cervical cancer if she
· Has her first sexual intercourse at a young age
· Has multiple sexual partners (increased risk of infecting with HPV)
· Having unprotected sex with multiple sexual partners(increased risk of infecting with HPV)
· Has a partner who has multiple sexual partners (increased risk of infecting with HPV)
· Has both sexually transmitted infection e.g. herpes and HPV infection which will significantly increased the risk of squamous cell cervical cancer.
Smoking
Smokers are more likely to develop squamous cell cancer. Researchers had found cancer causing chemicals (Benzyrene) from cigarette smoke in the cervical mucus of women who smoked. They concluded that these chemicals damaged the cervix. Langerhans cells in the lining of cervix will not function properly to fight against HPV causing mutation in cells which leads to cancer growth.
Smokers with HPV infection are twice likely to develop cervical cancer.
Personal hygiene
Development of Adenocarcinoma in cervix was almost half in women who bathed 6 or more times a week, compared to women who only bathed 1 to 5 times per week. Women with poor hygiene are more likely to get a lasting HPV infection if they are exposed to the virus.
Weakened immune system
A weakened immune system will hinder body defense against abnormal cells. Immune system will be unable to kill these abnormal cells and cancer may be formed. People with HIV and AIDS, or those taking drugs to suppress their immune systems after an organ transplant, are more at risk of developing cervical cancer if they also have HPV infection.
Genetics
Women with a first degree relative (mother, sister or daughter) diagnosed with adenocarcinoma or squamous cell carcinoma of the cervix is twice likely to develop cervical cancer compared to women without a family history.
Education and Poverty
Women in developing countries have a higher cervical cancer risk as they do not have access to screening due to poverty and a lacked of awareness on cervical cancer. Women who are poor are often undernourished; poor nutrition can also increase risk of cervical cancer.
Diet
Diets which are low in fibre and vitamins can also increase the risk of cervical cancer.
Lack of regular screening
Cervical Cancer is more common among women who do not have regular Pap tests. The Pap test helps doctor find precancerous cells. Treating precancerous cervical changes often prevents cancer. Between 60% and 80% of women with newly diagnosed cervical cancer have not had a Pap test in at least 5 years.
DES (Diethylstilbestrol)
DES is a synthetic estrogen prescribed to pregnant women to prevent pregnancy complications. Exposure to DES not only increased the risk of cervical cancer of the mother but also their off springs.
Prevalence
According to World Health Organisation, cervical cancer is the second biggest cause of female cancer mortality worldwide with 288,000 deaths yearly. About 510,000 cases of cervical cancer are reported each year with nearly 80% in developing countries: 68,000 in Africa, 77,000 in Latin America, and 245,000 in Asia. Cervical Cancer is the fifth most common cancer among Singapore women. Every year, about 200 women are detected with cervical cancer and about 100 die from the disease. The incidence of cervical cancer in Singapore has declined from 18.1 in 1968 to 10.6 per 100,000 women in 2002.Among the three major ethnic groups in Singapore; Chinese has the highest incidence rate of 11.5 per 100,000 women per year, followed by the Malays and Indians at 7.4 and 6.1 per 100,000 women respectively.
 http://www.hpb.gov.sg/hpb/default.asp?pg_id=1741
http://www.hpb.gov.sg/hpb/default.asp?pg_id=1741Symptoms
Like all cancer, cervical cancer in its early stage may have no symptoms and can exist for years undiagnosed (asymptomatic). It may only found upon medical testing.
However in advanced cervical cancer,
Ø Pain during sexual intercourse
Ø Pelvic pain. Persistent pelvic pain unrelated to other conditions, menstruation, or physical exertion can be a symptom of cervical cancer.
Ø Abnormal vaginal bleeding is the most common cervical cancer symptom. Women should be aware of post-coital bleeding, bleeding after douching, heavy periods, heavy spotting between periods, or an additional period during the monthly cycle. Any heavy, sudden onset of abnormal vaginal bleeding should be reported to the doctor immediately.
Ø Vaginal discharge. In advanced cervical cancer, a vaginal discharge may be present and may or may not have an odour.
Ø Unexplained weight loss
Diagnosis
PAP smear test
The PAP (Papanicolaou) smear test is a simple, quick, safe and relatively painless procedure for the detection of cervical cancer. Women aged between 25 and 69 who had sex before or are sexually active are advised to have a PAP smear done once every 3 years. PAP smears are available at all polyclinics, hospitals, most private clinics and Singapore Cancer Society.
A Pap smear is a screening test to check for changes in the cells of your cervix which may develop into cancer later. It is a simple procedure where cells are collected from your cervix and sent to a laboratory where the cells are examined under a microscope. It takes only a few minutes and can be done by a nurse or a doctor.

http://graphics8.nytimes.com/images/2007/08/01/health/adam/17116.jpg
Pelvic exam
It is an exam of the vagina, cervix, uterus, fallopian tubes, ovaries, and rectum. The doctor will inserts 1 or 2 lubricated, gloved finger of one hand into the vagina and places the other hand over the lower abdomen to feel the size, shape, and position of the uterus and ovaries. A speculum is also inserted into the vagina as the doctor looks at the vagina and cervix for signs of disease. A Pap smear test is usually done. The doctor will also insert lubricated, gloved finger into rectum to feel for lumps or abnormal areas.

http://www.plannedparenthood.org/images/PPFA/080000-Bimanual-Pelvic-Exam.gif
Colposcopy
If the Pap smear screenings test result is abnormal. The gynaecologist will use a diagnostic tool known as the Colposcopy to get a closer look at the cervix. During Colposcopy, colposcope (a lighted, magnifying instrument) is inserted into the woman’s cervix through the vagina. Gynaecologist can then focuses on areas of the cervix where light are inaccessible. Abnormal cervical changes are seen as white areas, the whiter the area, the worse the cervical dysplasia.

http://graphics8.nytimes.com/images/2007/08/01/health/adam/17041.jpg
Cervical Biopsy & Endocervical Cutterage
During Colposcopy, if abnormal cells are observed, doctor may perform a cervical biopsy in which samples of cells from the affected area will be taken out using small biopsy forceps. Similarly, an Endocervical Cutterage may be performed whereby a curett (spoon-shaped instrument) is used to scrape small amount of tissue from high inside the cervical canal. Samples of cells from both procedures will then be sent to the pathologist for examination.

https://www.beaumonthospitals.com/files/health-library/images/em_1998.gif
- Cone Biopsy & Loop Electro Surgical Excision
Cone Biopsy is used to diagnose cervical cancer and determine the extensiveness of the disease. A surgery is used to remove a cone-shaped piece of tissue from the cervix and cervical canal. LEEP uses a thin wire loop electrode which uses painless electrical current that quickly cuts away the affected cervical tissue in the surface area of the loop wire.
 http://www.thewomens.org.au/uploads/images/HealthInformation/FactSheets/wellwomens/LEEP.gif
http://www.thewomens.org.au/uploads/images/HealthInformation/FactSheets/wellwomens/LEEP.gif
http://www.uptodate.com/online/content/images/gyne_pix/Equipment_for_LEEP.jpg
Results
Once the biopsy results are out, cervical cancer can be determined to be of non existence, malignant or benign. If the cervical cancerous cells are malignant, doctor will then determine what stage the cervical cancer is in. There are eight stages in cervical cancer represent how serious and advanced has the cancer spread. Once a patient’s stage of cervical cancer has been determined, doctor can then decide on the treatment layout.
Treatment by Stages
Stage 0
Abnormal cells found in cervical epithelium. It may become cancer and spread into nearby cell
Loop electrosurgical excision
Laser Surgery
Conization (cone-shaped cells piece removed)
Cryosurgery ( abnormal tissue is frozen to destroy it)
Hysterectomy( removal of entire uterus)
Internal radiation therapy (localised radiation)
Stage 1A
Very small amount of cancerous cells found in the cervix only
Hysterectomy( removal of entire uterus) and removal of lymph nodes
Conization (cone-shaped cells piece removed)
Internal radiation therapy (localised radiation)
Stage 1B
Small amount of cancerous cells found in the cervix only
Internal radiation therapy (localised radiation) and external radiation therapy
Hysterectomy( removal of entire uterus) and removal of lymph nodes
Radiation therapy plus chemotherapy (drugs that kill cancer cells)
Stage 2A
Cancer spread beyond cervix to the upper 2/3 of vagina
· Internal and external radiation therapy
· Hysterectomy( removal of entire uterus) and removal of lymph nodes
· Radiation therapy plus chemotherapy (drugs that kill cancer cells)
Stage 2B
Cancer spread beyond cervix to the upper 2/3 of vagina and uterus
Internal and external radiation therapy with chemotherapy- Stage 3
- Cancer spread to lower third of vagina and to the pelvic wall and nearby lymph nodes Internal and external radiation therapy with chemotherapy
Cancer spread to bladder and lymph nodes in pelvis
Internal and external radiation therapy with chemotherapy
Stage 4B
Cancer spread beyond pelvis and pelvic lymph nodes to abdomen liver, intestinal tracts or lung
Treatment
- Radiation therapy as palliative therapy to relieve patient’s suffering and improve their quality of life
Chemotherapy
Clinical trials of new anti cancer drugs
Prognosis
Chance of recovery depends on the stage of cancer, type of cervical cancer and size of tumour.
Survival rates according to stages:
Stage 1A: Excellent Prognosis
Stage 1B: 87% to 90%
Stage 2A : 62 % to 83%
Stage 2B : 62% to 68%
Stage 3: 33% to 48%
Stage 4: 14%- Gardasil offers total protection against infection by two strains of the human papillomavirus, HPV, which account for 70 per cent of all cervical cancer cases. The vaccine is approved for use in girls and women between the ages of nine and 26. The vaccine has to be given in three doses. The vaccine works by building immunity against two of the worst offending human papillomaviruses - types 16 and 18. It also builds immunity against types 6 and 11, which cause almost 90 per cent of genital warts cases. Experts say the vaccine is most useful when given to younger girls. It is ineffective once the virus is present
Type of cervical cancer
Generally, the most common type of cervical cancer is the squamous cell cervical cancers which make up to 80% of patients suffering from cervical cancer. Approximately 10% of the patients are diagnosed with adenocarcinoma cervical cancer. A much smaller number of patients develop a form of cancer containing elements of both types. Less than 1% of the population will develop other very rare form cervical cancer. In other word, this means that prognosis for patient with a more common form of cervical cancer will be much higher than a patient with a rare form of cervical cancer since there is a better treatment layout for the more common form of cervical cancer as compared to the rare form of it. However, prognosis of cervical cancer is still highly dependable on the various stages of cervical cancer as compared to the type of cervical cancer.
Size of tumour
Tumours are abnormal masses of cell growth which can either be malignant or benign in nature. The size of cancerous tumour is another prognostic factor for cervical cancer patients. It is crucial to detect the disease while the tumours are relatively small become cancerous cells can divide very rapidly. If the tumours are detected early, cancerous cells are less likely to spread to other parts of the body and hence the chance of recovery for the patient will still be relatively high.
Extracted Cancerous Cervical

http://methodsofhealing.com/healing_conditions/files/2008/06/800px-cervical_carcinoma_with_adnexa1.jpg

http://www.all-health.co.uk/wp-content/themes/default/images/acrvcal.jpg
Possible Complications of Cervical cancer
- Without treatment
Metastasis may occur and give rise to secondary cancers at other parts of the body
Death
With treatment
Radiation Therapy – Inhibit ovarian function, premature menopause often occurs, vesicovaginal fistula (abnormal channel within pelvis which lead to incontinence through vaginal)
Hysterectomy –Unable to conceive, difficulty in emptying bladder or bowels, painful lower abdomen, urinary tract infections, bladder dysfunction, cysts and fistulas (abnormal channel within pelvis which lead to incontinence through vaginal)
Chemotherapy – Increased chance of infection from suppression of immune system, severe drops in white blood cell, liver and kidney damage, abnormal blood clotting (thrombocytopenia), allergic reaction to platinum-based agents, menstrual abnormalities, secondary cancers such as leukaemia (rarely), and long term problems with concentration, motor function, and memory due to reduction in estrogens levels after treatment.
Videos of Cervical Cancer
http://www.youtube.com/watch?v=M9rApbXndrs&feature=related
http://www.youtube.com/watch?v=hn8Jf6nfv7c
Blog references
http://www.cancer.gov/cancertopics/pdq/treatment/cervical/Patient
http://www.cancer.gov/cancertopics/types/cervical/
http://www.singaporecancersociety.org.sg/c_cervicalcancer.htm
http://www.cancerhelp.org.uk
http://www.hpb.gov.sg/hpb/default.asp?pg_id=865&aid=164
http://www.singaporecancersociety.org.sg/quest_answ.htm#cervical
http://www.cancer.gov/cancertopics/pdq/treatment/cervical/Patient
http://www.cancer.gov/cancertopics/pdq/treatment/cervical/Patient/page5
http://www.cancer.gov/cancertopics/pdq/treatment/cervical/Patient
http://www.singhealth.com.sg/Newsroom/NewsReports/2006/KKH_cervical+cancer+vaccine.htm
